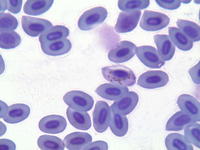
Estudian la coevolución de los parásitos de la malaria aviar y los mosquitos que la transmiten

Naturaleza

Rosa Aguilar defiende en Oslo un compromiso internacional vinculante para la protección de los bosques

El programa de voluntariado para la crianza de Ibis eremita, desde este miércoles en Sierra del Retín

España copresidirá con Noruega la VI Conferencia Ministerial sobre la protección de los bosques en Europa

SEO/Birdlife e Izate valoran la desición de REE de no pasar tendido por un corredor ecológico entre Cantabria y Vizcaya

Ecologistas dicen haber detectado 3,8 kilómetros más de litoral afectado por vertidos en el Parque Natural del Estrecho